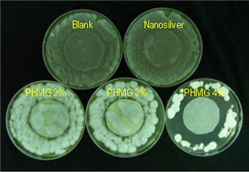
Penicillium citrinum(ATCC9849)
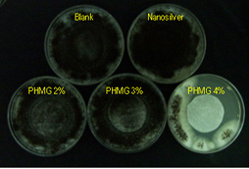
Aspergillus niger(ATTCC9642)

Purificadores de Aire
Aire puro, fresco y sano

¡Ventaja Extraordinaria!
Elimina el humo del cigarro al instante y protege un 99.9% de los virus en el aire.
CAP G2800

The CAP G2800 is our room sized air purifier, and has been designed to efficiently and effectively clean the air in an area up to 450 square feet...
Features
The CAP G2800 is our room sized air purifier, and has been designed to efficiently and effectively clean the air in an area up to 450 square feet. The CAP G2800 air purifier provides an efficient and cost effective method of removing indoor air pollutants. By using a powerful 4-speed fan with ultra quiet motor technology, air is passed through a four stage filtration system consisting of a pre-filter which catches large dust particles and hair, a HEPA filter which removes 99.97% of particulates larger than 0.3 microns, an activated carbon filter which eliminates odors, and a sterilization filter which destroys bacteria.
Included Accesories
- The BY150 Air Cleaner
- Remote Control
- A Battery
- User's Manual
- 1 Pre-Filter
- 1 HEPA Filter
- 1 Activated Carbon Filter
- 1 Sterilization Filter
Recommended Accesories
 Permanent Filters AGPF150 for CAP G2800 Air Purfier Cleaner
Permanent Filters AGPF150 for CAP G2800 Air Purfier Cleaner Activated Carbon Filters AGCF150 for CAP G2800 Air Purifier Cleaner
Activated Carbon Filters AGCF150 for CAP G2800 Air Purifier Cleaner True HEPA Filters AG150HEPA for CAP G2800 Air Purfier Cleaner
True HEPA Filters AG150HEPA for CAP G2800 Air Purfier Cleaner
Specifications
| Model | CAP G2800 |
|---|---|
| Coverage Area | 300-450 square feet |
| Filtration Technology | 4 stages - pre-filter, HEPA filter, activated carbon, and sterilization filter |
| Dimensions | 17.4" L x 10.6" W x 16.6" H |
| Gross Weight | 20 lbs |
| Numbers of Fan Speeds | 4 |
| Control Type | Both remote and manual |
| CADR Delivery Rate | 116 |
| Watts | 65 watts |
| Voltage | 110-120 volts |
| Fan Motor | AC Motor |
| Noise Level | Under 45dB (on maximum setting |
| Warranty | 1 year |
| Automatic Operation with Filter Replacement Indicator | |
CAP G4022

CAP G4022
The CAP G4022 is today's most advanced and effective air purifier designed for home and office use.
In independent laboratory tests performed by the Association of Home Appliance Manufacturers, the CAP G4022 air purifier had the highest Clean Air Delivery Rate (CADR) when compared to 159 leading air purifiers.
Extremely Effective at removing tobacco smoke, dust, pollen, and mold spores, animal dander and other indoor air pollutants.
Perfect for spaces up to 1500-2000 square feet.
Features
Features Only the CAP G4022 air purifier offers you all these advanced, innovative features:
• Highest Clean Air Delivery Rate (CADR) among 159 air purifiers and air cleaners tested by the Association of Home Appliance Manufacturers. Pollutants get removed before they can create or worsen health problems.
• 12-Stage Filtration: 4 permanent & washable Pre-filters, 4 HEPA filters (99.97% effective at removing particles as small as 0.3 microns), 2 Activated carbon filters, 2 washable high airflow filters (air filtration media with antimicrobial agent). Allergens can't hide from the CAP G4022!
• Large Effective Coverage Area: Covers 1500-2000 sq ft. with two air changes per hour.
• Continuous Air Quality Monitoring: Sensor checks pollution level in your environment and automatically adjusts fan speed for best performance.
The CAP G4022 air purifier also provides:
• Advanced Programmable LCD Control Panel: Lets you easily adjust time and speed setting, auto/manual mode, and other controls
• Variable Timer: Can be set so that unit shuts off after 1 to 8 hours of operation
• Light Sensor for Silent Mode: Switches purifier to silent mode when room is dark - ideal for bedrooms and living rooms
• Ultra-Quiet Motor Technology: Advanced BLDC motor operates at choice of five speeds - completely silent at lowest speed
• From Environmentally Safe Materials: The CAP G4022 is "Green"
And there's even more!
• Handy Remote Control: Operates the unit remotely or from the front panel
• Easy-to-Replace Filters: No screwdriver needed
• Clean and Replace Indicator: Monitors usage and operating conditions to reminds you when the filters need attention
• Aromatherapy Capability: Emits a pleasant aroma
• Easy to Move: Heavy-duty, easy-glide casters let you move unit effortlessly from room to room
• Stylish Design: Looks great in any room of home or office
• Ozone-Free Technology: All Airgle air purifiers produce absolutely NO ozone. Ozone is a lung irritant that's emitted from ionic air cleaners.
How the Unit Works? The air purifier uses a powerful fan to draw air through an intake grill in the bottom of the unit. The air then passes through the 12-stage filtration system, which traps the airborne particles and reduces allergens and odors.
- Pre-filter catches hair and large dust particles.
- High Airflow filter comes with Antimicrobial Agent technology that can effectively remove particles.
- HEPA filter removes dust, pollen, smoke, dander, and other small particles.
- Activated carbon filter (deodorization filter) eliminates harmful gases, odors and VOCs.
Recommended Accesories
 Permanent Filters AGPF750 for CAP G4022 Air Purfiers Cleaners – Package of 4 for
Permanent Filters AGPF750 for CAP G4022 Air Purfiers Cleaners – Package of 4 for  Activated Carbon Filters AGCF750 for CAP G4022 Air Purfier Cleaner
Activated Carbon Filters AGCF750 for CAP G4022 Air Purfier Cleaner  True HEPA Filters AG750Filter4 for CAP G4022 Air Purfier Cleaner –Package of 4
True HEPA Filters AG750Filter4 for CAP G4022 Air Purfier Cleaner –Package of 4  Fragrance Cartridge AGFC750 for CAP G4022 Air Purfier Cleaner
Fragrance Cartridge AGFC750 for CAP G4022 Air Purfier Cleaner

Specifications
| Model | CAP G4022 |
|---|---|
| Number of Air Changes | 2 per hour |
| Fan Settings | 5 |
| Coverage Area | 1500-2000 square feet |
| Filtration Technology | 12 stage - 4 pre-filters, 4 HEPA filters, 2 activated carbon filters, and 2 high airflow filters |
| Dimensions | 20.8" L x 14" W x 26.4"H |
| Gross Weight | 37 lbs |
| Numbers of Fan Speeds | 4 |
| Control Type | Both remote and manual |
| CADR Delivery Rate | 116 |
| Watts | 65 watts |
| Voltage | 110-120 volts |
| Fan Motor | BLDC |
| Noise Level | Under 54.8 dB (on maximum setting) |
| Warranty | 1 year |
| Display | LCD control panel |
| Variable Timer and Light Sensor Mode • Filter Clean and Replace Indicator • Easy-Glide Casters | |

Comments and Reviews
Airgle, NYC
The CAP G4022 has an advanced filter monitoring system. monitoring filters and signal as cleaning and/or replacing is needed. All filters are easy to access and change with no need for tools. The indicator is very helpful in providing the status of the filters and filter check function allows you to check the filters whenever desired. We recommend cleaning pre filters every 4-5 months.
Airgle Corporation, NYC
In independent laboratory tests performed by the Association of Home Appliance Manufacturers, the CAP G4022 air purifier had the Highest Clean Air Delivery Rate (CADR) when compared to 159 leading air purifiers on the market. Airgle: Purifying Air with a Great Level of Efficiency
¡Contáctenos para Cotizar!
CAP M3012

CAP M3012 (old model)
PEC-ion System; PhotoElectroCatalytic-ion System By using Oxidation of Photo - catalyst reaction & High Voltage Discharge Technology, this technology can oxidize VOCs into Carbon dioxide (CO2) & H2O.
As a complex way of air purifier, CAP3000 series have not only outstanding eliminating capacity of micro-dust, particles etc but also outstanding sterilizing capacity so that they can eliminate Influenza virus.
Specifications
| Model | CAP M3012 |
|---|---|
| Dimensions | 400X270X547(mm) |
| Net Weight | 10Kg |
| Watts | 45 watts |
| Voltage | Customer Oriented |
- Design of the exterior cover is optional(Over basic quantity)
- Functions(filters) of the air purifier are optional according to the condition of the place(Over basic quantity).
- 3012 model: PEC-ion system
- 3010PD model: Plasma complex system
PEC-ion System; PhotoElectroCatalytic-ion System
CAP3000 series have 12 steps of PEC-ion system At the normal temperature, this technology can eliminate *VOCs more excellently than other air purifier products. By using Oxidation of Photo - catalyst reaction & High Voltage Discharge Technology, this technology can oxidize VOCs into Carbon dioxide(CO2) & H2O.
As a complex way of air purifier, CAP3000 series have not only outstanding eliminating capacity of micro-dust, particles etc but also outstanding sterilizing capacity so that they can eliminate Influenza virus.

Plasma Anion- Forest-Bathing Efficiency
Anion Generator is built in and it generates over 50k to 100k pcs of Anion(cc/piece) and makes fresh air such as he air around Forest or Waterfall.

This air purifier does not rely on ozone as part of the air cleaning process. Our producs are ozone safe as the proper authoritty tested.
Features

- Digital LED
- Remote Control
- "Sleeping" function : Low noise operating
- Artificial Intelligence alarm function: Indicates exchanging time of HEPA filter and Alarm bell is ringing in case of faults or malfunctions of products
- "Going-out" function : While one is out or sleeping
- Artificial Intelligence sensor : Automatic operating according to the level of air pollution inside
- PEC-ion System; PhotoElectroCatalytic -ion system
- Elimination of Carbon Monoxide(CO) World First Technology
- Elimination of Volatile Organic Compounds
- Elimination of Influenza Virus
- Certified by Biotechnology Industrialization Institute of engineering college, Yonsei University, Korea
Complex type of 12 steps air purifying filter system

7steps of euro PEC system - By making airflow euro type, maximize dust collecting efficiency

5steps of complex HEPA filter
HEPA filter eliminate micro-dust by 99.97% and Carbon filter strongly eliminate bad odor.
What is Mugu's Nano Metal Carbon filter?
The catalytic material such as Nano-copper or Nano-silver is sprayed onto the natural activated carbon pieces. Powerful performance and deodorizing, not only by simple absorbing but also by catalytic disintegrating mechanism.
Nano Metal Carbon filter's Performance

Test for Ammonia disintegration rate
Comparing the disintegration rate of regular carbon filter and Nano-matal carbon filter
What is Sky-Bio?

Human Influenza A-type Test Report (Avian Influenza #7 are variations from Human Influenza A-type)
Tester: AMS Laboratories Pty Ltd, Australia
Ref. #0502111, on February 18, 2005
Applied by: SK Chemicals Co.,Ltd. Korea
Results: A-type Influenza eliminated in 10 minutes. -> Test report posted on our webhard ...The test run with 1% Skybio, filters treated with 4% Skybio...
Anti-bacteria effect with Guacil TX
100% decreasedin 18 hours!
- Tested with non-woven fabrics Spunbond, treated with 3% *Ref#. KS K 0693-2001
- Tested bacteria: Staphylococcus aureus(ATCC 6538), Klebsiella pneumonia(ATCC 4352)
| K.pnoumonia | Blank | Nanosilver | Skybio(3%) | Skybio(4%) |
|---|---|---|---|---|
| Beginning | 1.2x10s | 1.2x10s | 1.2x10s | 1.2x10s |
| in 18 hours | >106 | >106 | none | none |
| Decrease (%) | - | 0 | 100 | 100 |
ATCC 6538

ATTCC 4352

- 100% sterilized with 3%
- Filters treated with 4%
Mold Sterilization Effect with GUACIL
Methods- ASTM G21 Method
Molds-Penicillium citrinum(ATCC9849) / Aspergillus niger(ATTCC9642)
The Pictures of test results Halo zone was made with SKYBIO 4%
1. ASTM G21
Penicillium citrinum(ATCC9849)
Aspergillus niger(ATTCC9642)
¡Contáctenos para Cotizar!